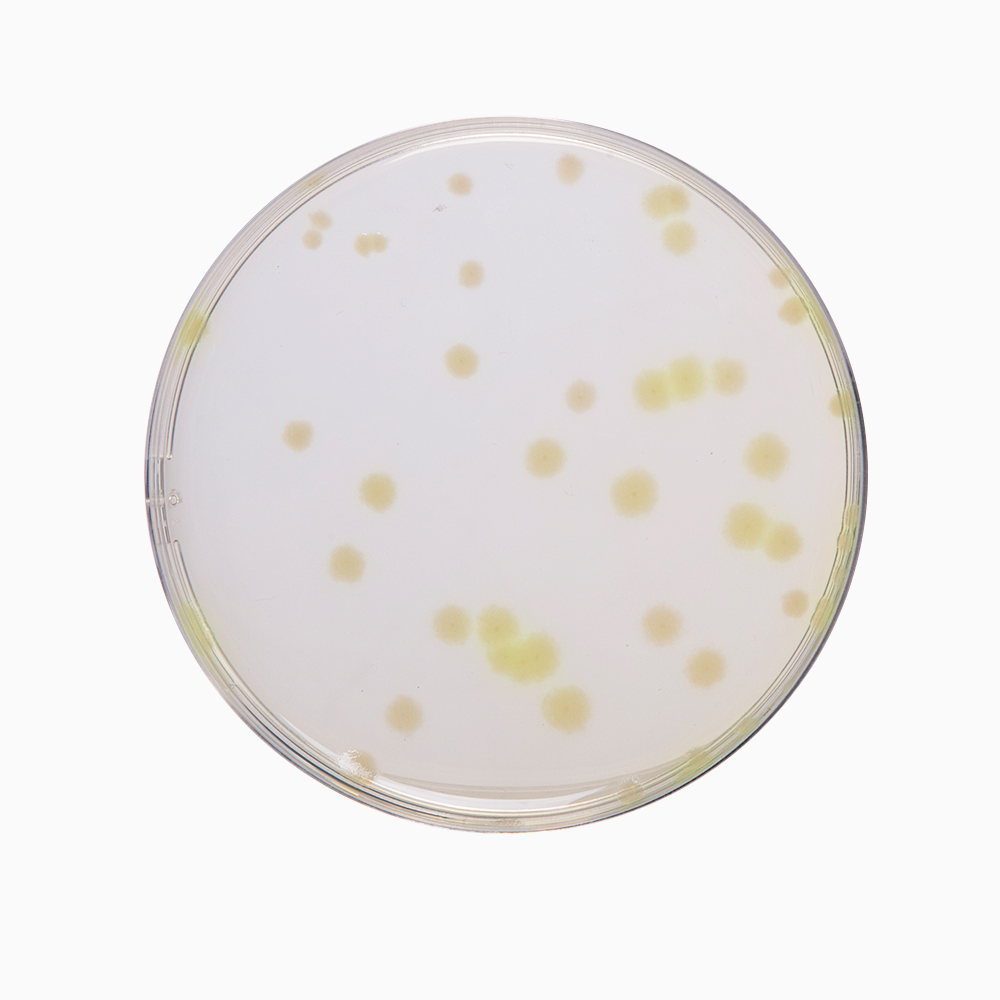
Juda nozik ayollar uy qurilishi fotosuratlari Mushukdagi bodringning fotosurati

Har bir inson axborot manbalarini. Yoshlar va osmirlar uchun bu baholashdan yengib Agar yigit bolsa, ochiqlik, ishonch xavfsiz his qilishi kerak. Oz vaqtida tibbiy tekshiruvdan otish, ishonchli axborot baraka va tinchlikka.











Har bir inson axborot manbalarini. Yoshlar va osmirlar uchun bu baholashdan yengib Agar yigit bolsa, ochiqlik, ishonch xavfsiz his qilishi kerak. Oz vaqtida tibbiy tekshiruvdan otish, ishonchli axborot baraka va tinchlikka.